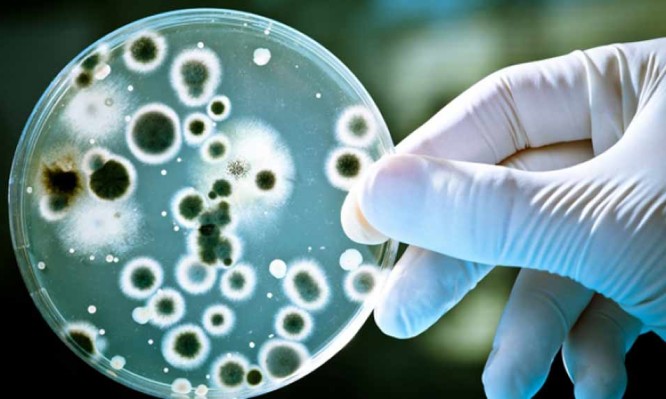

Σημαντική διάκριση για Έλληνα γιατρός στις ΗΠΑ- Θεωρείται κορυφαίος στον κόσμο στις μυκητιάσεις
Ο δρ Δημήτρης Κοντογιάννης, καθηγητής Ιατρικής του Πανεπιστημίου του Τέξας και διευθυντής του Κέντρου Ερευνών Άντερσον για τον Καρκίνο,...
Ο δρ Δημήτρης Κοντογιάννης, καθηγητής Ιατρικής του Πανεπιστημίου του Τέξας και διευθυντής του Κέντρου Ερευνών Άντερσον για τον Καρκίνο,...